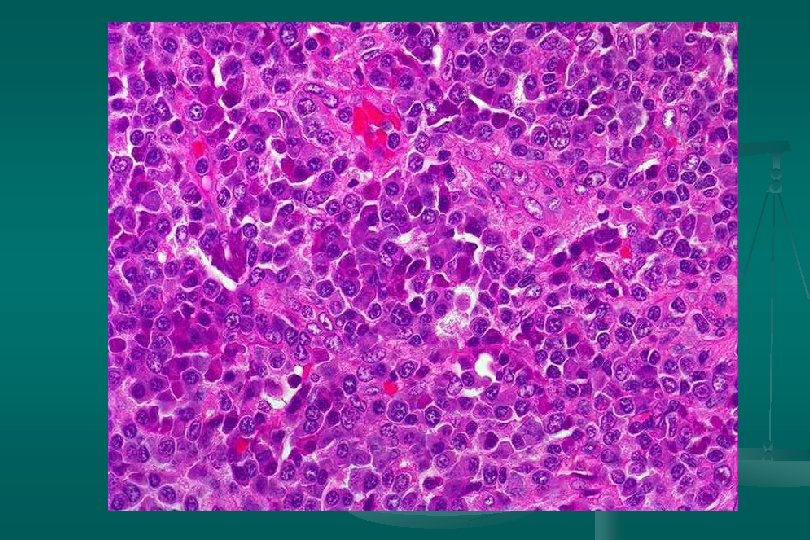

Hiperplasias Linfoides Reactivas Curso de Hematopatologa Estudio de





















- Slides: 21

Hiperplasias Linfoides Reactivas Curso de Hematopatología

Estudio de ganglio Linfático n n n n BAAF Biopsia excisional Fijación en formalina buferizada 10 % Tejido fresco Citometría de flujo, PCR, Ténicas moleculares Inmunohistoquímica Tinciones especiales






Linfadenitis aguda Histología: 1. Dilatación de los senos: incremento del flujo de linfa. 2. Acumulación de neutrófilos 3. Dilatación vascular 4. Edema de la cápsula n Linfadenitis supurativa: Estafilococo, L. mesentérica, linf. venéreo, enf. añarazo gato n

Linfadenitis Crónica no Específica n n n Histología: Hiperplasia Linfoide reactiva Vénulas poscapilares prominentes Incremento de inmunoblastos, células plasmáticas, histiocitos y fibrosis Inflamación de la cápsula y/o fibrótica Extensión perinodal

Linfadenitis crónica no específica n n Algunos casos: incremento de neutrófilos, macrófagos espumosos y/o mastocitos Linfadenitis eosinofílica o xantogranulomatosa: sin significancia etiológica.


Linfadenitis crónicas específicas n n n Tiene un patrón histológico reconocible Sospecha de la etiología Requiere confirmación cultivo, serológica o inmunológica.

Enfermedad de Castleman Histología: dos categorías: 1. Tipo vascular hialino (angiofolicular): n Folículos grandes, proliferación vascular y hialinización central. n Capas concéntricas de linfocitos en la periferia del folículo (capas de cebolla). n Estroma interfolicular: prominente, venulas poscapilares hiperplásicas, CP, E. inmunoblastos n

Enfermedad de Castleman Subtipo linfoide: *Expansión zona del manto *Centros germinales pequeños. 2. Tipo células plasmáticas: n Proliferación difusa de cels plasm interfolicular + cuerpos de Russell n Cambio vascular-hialino: ausente n Depósito de material acidofílico amorfo (fibrina y complejos inmunes) n

Enfermedad de Castleman Clínica: 1. Forma solitaria: *Masa localizada *Mas común en mediastino. *Además: cuello, pulmón, axila, mesenterio, retroperitoneo, tejidos blandos. n Macroscopía: *Redondeado *Circunscrito *Tamaño: 15 cms o más. n Histología: +90% = tipo vascular hialino. n Tratamiento: excisión n

Enfermedad de Castleman 2. Forma sistémica o multicéntrica: *Tipo cels plasmáticas*Linfadenopatía generalizada/ bazo. n Pronóstico: pobre n Complicación: renal, pulmonar n Tipo vascular hialino: asociado a sarcoma de células fusiformes